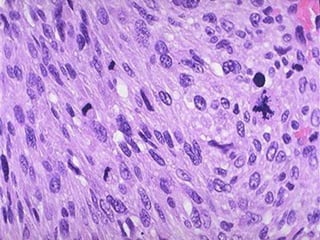
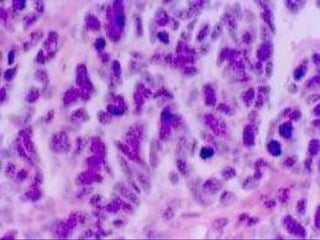

Este documento presenta una descripción general de la patología de cabeza y cuello, con énfasis en la cavidad oral y nasofaringe. Se describen varias lesiones benignas y neoplasias malignas comunes en estas regiones, incluyendo papilomas, verrugas, condilomas, leucoplasia, eritroplasia y diferentes tipos de carcinomas. También se proporcionan detalles sobre la epidemiología, factores de riesgo y pronóstico de algunos de estos tumores.